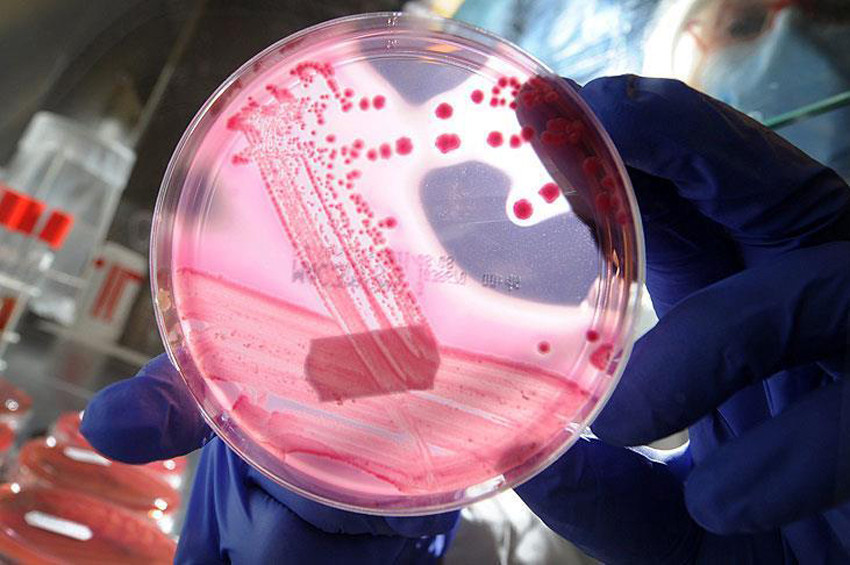
2017nin en dikkat çeken 10 bilimsel buluşu

Yılın en büyük 10 buluşu arasında gösterilen kolon kanser tedavisinde yüzde 100 başarı elde edilmesini sağlayan üç etaplı radyoimmünoterapi yöntemi, bilim dünyasında yeni kapıları araladı.
Orta Doğu Teknik Üniversitesi (ODTÜ) Kimya Bölümü Öğretim Üyesi Prof. Dr. Ural Akbulut, uluslararası dergiler Science ve Nature ile önemli bilimsel konferanslar gibi kaynaklardan, 2017'de dünya bilim dünyasında yaşanan önemli gelişmeleri, yüzlerce buluş arasından derledi.
Buna göre, 2017'nin en etkileyici buluşları arasında, ABD Massachusetts Institute of Technology'de (MIT) Prof. Dr. Xuanhe Zhao ve ekibinin 3D yazıcıda genetiği değiştirilmiş canlı hücreleri mürekkep gibi kullanarak üç boyutlu baskı yapmayı başarması oldu.
Araştırmacılar, suda çözülebilen bir polimer, su ve besinle hazırladıkları hidrojelin içine bakterileri ekleyip yazıcının haznesine doldurdu. Yazıcıda elde edilen şekildeki çizgiler, 30 mikron kalınlığındaydı. Bu teknikle, giyilebilir sensörlerin üretilmesinin düşünüldüğü açıklandı. Kullanılan hücreler uygun şekilde programlanarak çevre kirliliği yaratan kimyasalların algılanabileceği belirtildi. Çalışma, Advanced Materials dergisinde yayımlandı.
- Üç etaplı radyoimmünoterapi ile kolon kanser tedavisi
ABD'de MSK Kanser Merkezi ve MIT'nin ortak çalışması sonucunda geliştirilen üç etaplı radyoimmünoterapi tekniğiyle toksik bir etki olmaksızın kolorektal kanser tedavisinde yüzde 100 başarı elde edildi. Bu çalışmada, A33 tümör antijenine özgü bir antikor, lütetiyum-177 kompleksi ve özel bir organik bileşik kullanılarak glikoprotein A33 (GPA33) hedeflendi. Araştırmacıların geliştirdiği özel organik bileşiğin önemli bir rolü olduğu açıklandı.
Araştırmacılar, bu bileşiğin kanser hücrelerini bulup ardından da onları yok ederek kanseri tedavi ettiğini belirtti. Hayvan deneylerinde başarılı olan bu yöntemin insanlara uygulanabilmesi için çalışmaların başlatıldığı belirtildi. Çalışma, The Nuclear Medicine dergisinde yayımlandı.
- Soğuk algınlığını tedavi edecek virüsün kodu çözüldü
Leeds, York ve Helsinki üniversitelerindeki araştırmacılar, soğuk algınlığının kesin tedavisinin çok yakın olduğunu açıkladı. Açıklamada, insan parechovirüsünün genetik kodu çözüldüğü için soğuk algınlığının tek bir ilaçla tedavi edilebileceği belirtildi. Buluş ile virüslerin kendilerini yenilese bile tek bir ilaç tasarlanarak soğuk algınlığının tedavi edilebileceğini gösterdiği vurgulandı. Yeni ilacın sentezlenerek testler tamamlandıktan sonra kullanılmaya başlaması için 10 yıl gerektiği aktarıldı. Çalışma, Nature Communications dergisinde yayımlandı.
- Deniz suyu tatlı suya dönüştürüldü
Daha önce grafen oksit membranlar kullanılarak bazı moleküller ve büyük boyutlu tuzlar filtrelenebilmişti. Ancak 2017'de ilk kez Manchester Üniversitesinde deniz suyundaki tuzlar, grafen oksit filtreyle filtrelenerek saf su elde edildi. Prof. Dr. R. R. Nair, bu sistemi bir evin ihtiyacını karşılayacak boyutta ve düşük bir maliyette üretecek tesisler kurulmasını hedeflediklerini açıkladı. Açıklamada, bu gerçekleşirse gelişmemiş ülkelerde susuzluk çeken ailelerin temiz içme suyuna kavuşabileceği vurgulandı. Çalışma, Nature Nanotechnology dergisinde yayımlandı.
- Bir hücrenin üzerindeki virüsü gösteren mercek
Vanderbilt Üniversitesinde Doç. Dr. J. Caldwell, boron nitrür kristallerini kullanarak canlı hücreleri ve üzerlerindeki virüsleri gösteren bir hiper mercek geliştirdi. Bor nitrür kristali ile yapılan hiper mercek, nano boyuttaki canlı organizmaları inceleme olanağını doğurdu. Araştırmacılar, merceğin insan saçının üç binde birine karşılık gelen 30 nanometre boyuttaki objeleri görüntüleyecek şekilde geliştirileceğini açıkladı. Çalışma, Nature Materials dergisinde yayımlandı.
- Yarı iletkenlerle kaplanan bakteriler, güneş ışınıyla yakıt üretti
Berkeley ve Harvard üniversiteleri araştırmacılardan Dr. P. Yang ve Dr. K. Sakimoto, bakterilerin dış yüzeyini yarı iletken madde ile kaplamayı başardı. Bu bakteriler, güneş enerjisini emerek yakıt olabilecek organik madde üretti. Bu çalışmada, bazı bakterilerin kadmiyum gibi ağır metalleri kükürtlü bileşiklere dönüştürme özelliğinden yararlanıldı. Araştırmacılar, besin ekledikleri suda bakterileri çoğalttıktan sonra karışıma kadmiyum tuzu kattıklarını ve bir süre sonra bakterilerin yüzeyinin kadmiyum sülfürle kaplandığını açıkladılar. Yüzeyi kadmiyum sülfürle kaplı bakteriler, güneş ışınları yardımıyla su ve karbondioksitten asetik asit üretti. Asetik asit üretimindeki veriminin yüzde 80 olduğu açıklandı. Çalışma, Washington'daki ACS Konferansı'nda sunuldu.
- Mikrobiyal yakıt pilinde yenilik
SUNY-Birmingham Üniversitesinden Yrd. Doç. Dr. S. Choi, birbirine destek veren iki ayrı bakteri türünü kullanarak yeni bir mikrobiyal yakıt pili geliştirdi. S. Choi, iki tür bakterinin olduğu çözelti güneş ışınları altındayken, çözeltiye biraz besin eklediklerini açıkladı. Besin eklenince, heterotrofik bakteriler çoğalıp karbondioksit üretmeye başladı. Karbondioksit, fototrofik bakterilerce kullanılmaya başlanıp simbiyotik bir düzen kurulunca S. Choi, heterotrofik bakterilere besin eklemeyi kesti. Pil, besin eklemeye gerek kalmadan 13 gün çalıştı ve 8 mikroamper/santimetrekare akım üretti. Çalışma, Power Sources dergisinde yayımlandı.
- Biyomolekülleri yakalayan grafen cımbız
Minnesota Üniversitesinden Prof. Dr. Sang-Hyun Oh ve ekibi, grafenden yaptıkları elektronik sistemle, bir çözelti içindeki biyomolekülleri tek tek yakalamayı başardı. Araştırmacılar, bu sistemin ilerde bazı hastalıkların teşhisi için kullanılabileceğini aktardı.
Sistemin küçüklüğü ve bir voltla çalışıyor olması nedeniyle cep telefonu yardımıyla kullanılabileceği vurgulandı. Nano boyuttaki bu grafen cımbız, hafniyum dioksit adlı yalıtkan maddenin bir yüzüne metal elektrot, diğer yüzüne de grafen yerleştirilerek üretildi. Araştırmacılar, çözeltideki biyomolekülleri yakalamak için en keskin uçlu malzemenin kullanılması ve bu uca yüksek elektrik akımı gönderilmesi gerektiğini ifade etti.
Dünyadaki en ince malzeme olan grafenin, en keskin kenarlara sahip olduğu için tercih edildiği belirtildi. Grafenin kenarları sadece bir atom kalınlığında olduğu için bu kenarda santimetrekareye düşen akımın seviyesi, bir voltluk güç kaynağı ile istenilen yüksek düzeye ulaştı. Çalışma, Nature Communications dergisinde yayımlandı.
- Optik bilgisayarın önü açıldı
Imperial College'da, optik bilgisayarı yapabilmek için gereken bir teknik geliştirildi. Üniversiteden Dr. M. Nielsen ve ekibi, silisyum bir tabakanın üzerini MEH-PPV adlı bir polimer (plastik) ile kapladı. Ardından da polimerin üzerini altınla kaplayarak ışınların birbirleriyle çok kısa mesafelerde etkileşmesini sağlayan bir elektronik yonga yapmayı başardı. Optik bilgisayarların önünü açan bu çalışma, Science dergisinde yayımlandı.
- MIT’te üç boyutlu grafen üretildi
MIT'te yapılan çalışmalar, grafen hakkındaki bazı bilgilerin yanlışlığını kanıtladı. Prof. Dr. Z. Qin, grafenin normal koşullarda sanıldığı gibi en güçlü malzeme değil, yoğunluğunun da havadan düşük olmadığını açıkladı. Araştırmacılar, grafenin üç boyutlu yapısını model alarak, farklı malzemelerden 3D yazıcıyla ürettikleri plastik malzemelerin de normalinden daha güçlü hale geldiğini açıkladı. Çalışma, Science Advances dergisinde yayımlandı.

Yorumlar